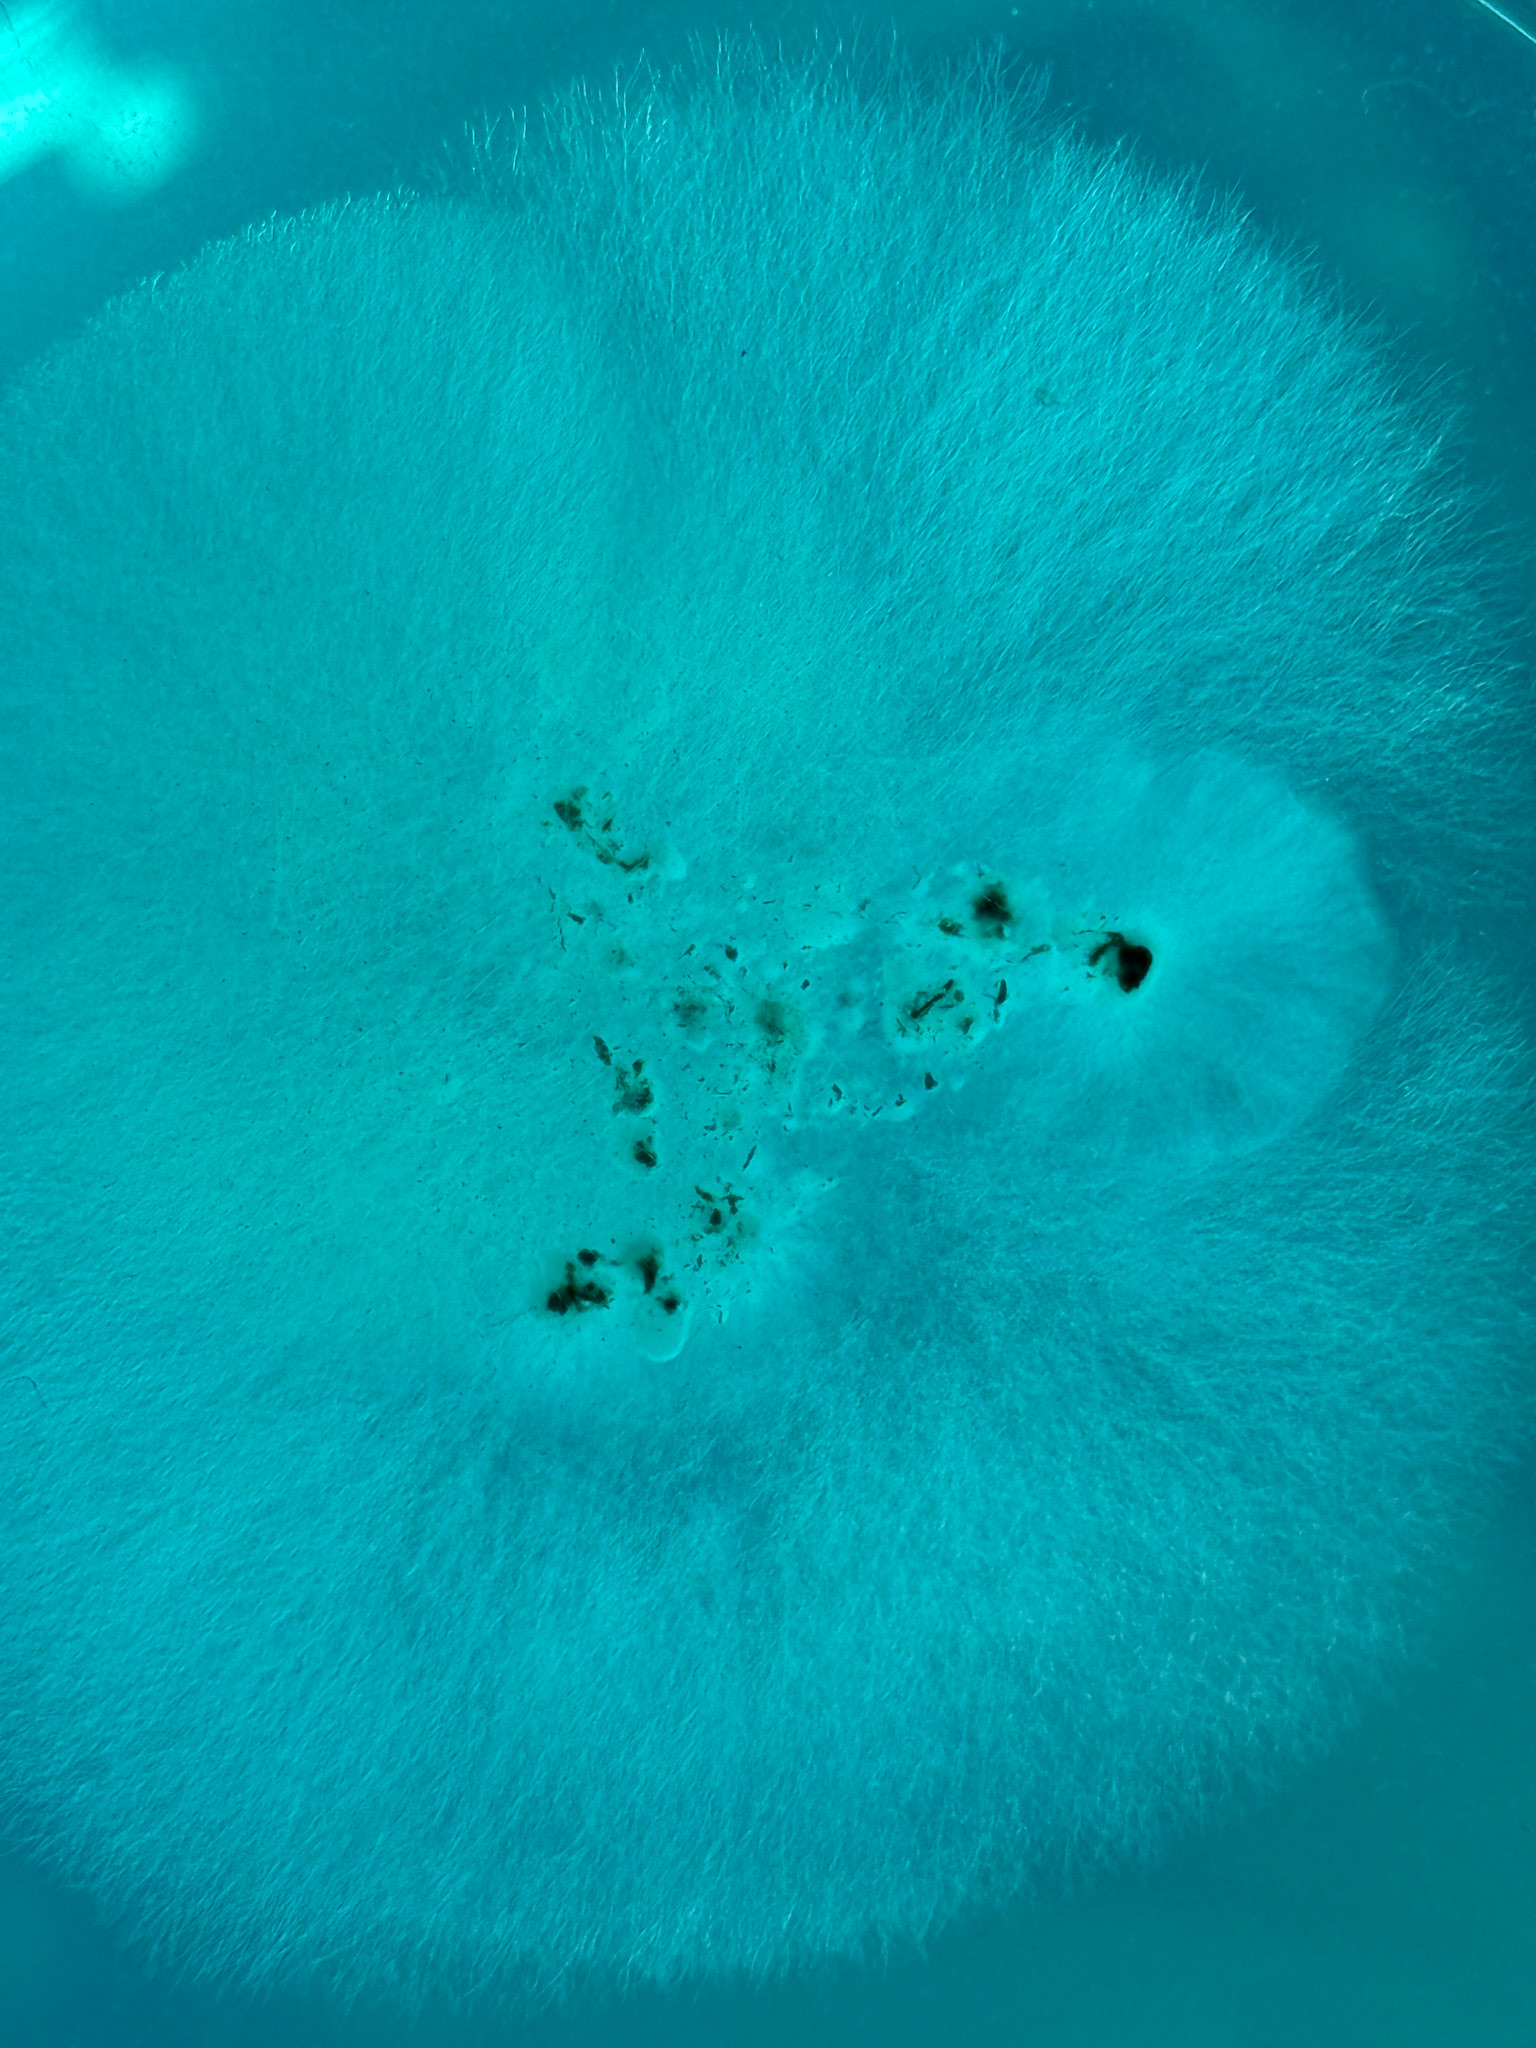

Peatlands are unique and rare ecosystems that store up to one-third of the world’s soil carbon. They support a wealth of biodiversity, yet are increasingly under threat from climate change and human activity.
I am currently developing an immersive arts project that seeks to reconnect humans with these living, breathing landscapes — promoting knowledge exchange and highlighting alternative ways of seeing, living with, and caring for the Earth.
Through visual, auditory, and sensory immersive techniques, I blend digital and analogue methods and explore both scientific and artistic approaches to practice-based research. This includes fieldwork, 3D scanning, video projection mapping, and soft sculpture — all used to communicate the urgency and importance of preserving our peatlands by examining them from the air, their surfaces, and the soil below.